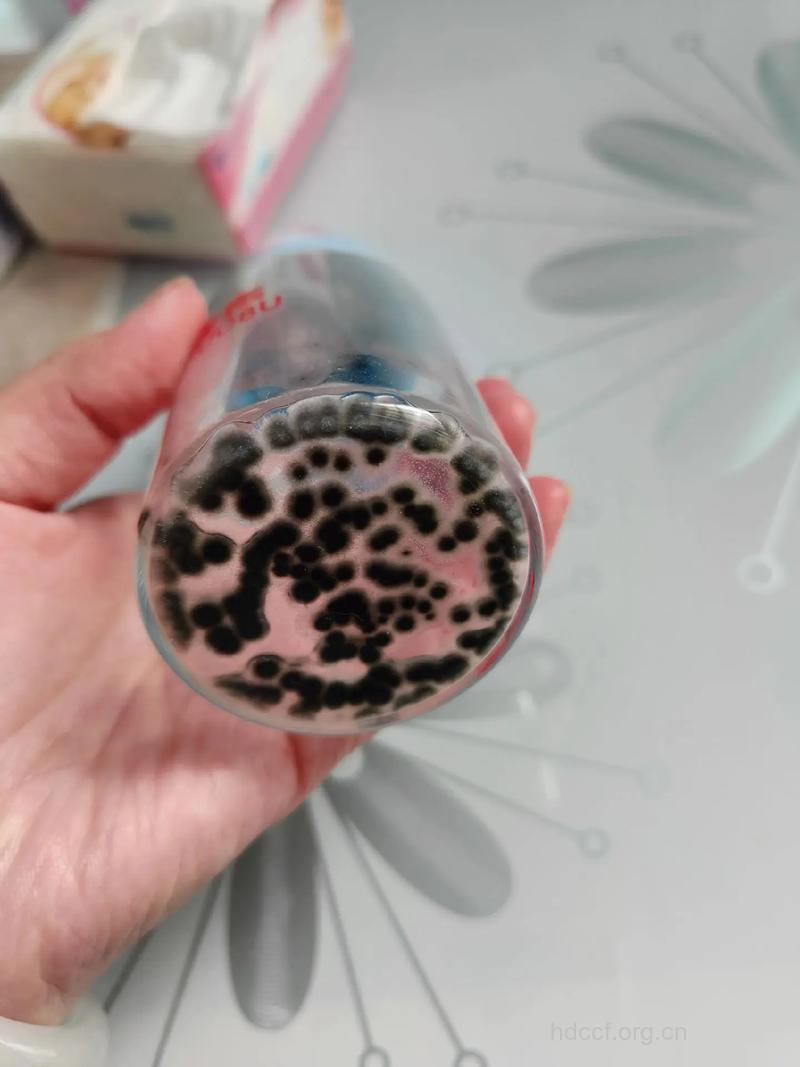
女人身边隐藏的的七大细菌温床

编辑推荐:补脑必吃的十种健康食物
卫生巾和护垫可谓是与女性最亲密的用品了,但这些直接接触我们私密部位的东西,如果使用不当,会变成可怕的“细菌炸弹”,而且能直接命中“靶心”,让我们生病。
解决方法:经常更换。卫生巾和护垫最好都是每2-4小时更换一次,而且每次更换前一定要先洗手,不要用不干净的手接触卫生巾和内裤。保存在干燥的地方。很多女性喜欢把这些卫生用品保存在浴室里,但浴室通常不通风且潮湿,很容易滋生霉菌,外包装被拆开后的卫生巾并不密封,就这样被污染了。而且保存太久的卫生巾会失去无菌状态,所以最好每月购买,切忌一次囤很多。
随身携带的粉扑和化妆刷是细菌丛生之处,因为在外面补妆的时候,往往是处于手也不干净、脸也不干净的状态,粉扑很容易就变得黄黄黑黑的。
解决方法:定期整理化妆包。每星期清洁和整理一次化妆包的必要性应该不用赘述了。另外一个重点就是,还要清出那些已过期和已用完的化妆品。粉扑和化妆刷都可以用中性洗涤剂来清洗,洗干净以后放到通风处阴干就可以了。
精彩阅读:最坑人的8种“健康食品” 让你女人越吃越年轻的食物
编辑推荐:补脑必吃的十种健康食物
人们通常不会在意自家拖鞋的清洁,殊不知,你的脚和袜子还带着皮鞋和跑鞋里的污垢细菌,洗完澡后再穿上同一双拖鞋,然后被拖鞋“污染”过的脚再伸进温暖的被子。
解决方法:常常清洁鞋子。家中每人准备两双拖鞋。这是最彻底的清洁方法,一双是从外面回家以后穿的,另一双则是洗完澡之后穿的,彻底“内外分开”,再也不怕鞋子里的细菌传到床上了。另外要提醒的是,袜子一定要和内衣裤分开清洗。
我们整天带在身边的心爱包包,其实正是最大的细菌源之一。首先,包包被放置在各种场合的沙发、椅子、桌子上,它的外部表面最容易被各种各样的污垢和细菌“盯上”。
而包包的内部也无法幸免,常会被我们随手扔进包里的物品污染,钥匙、手机、钱包、纸巾这些经常拿进拿出的东西本身就带有不少细菌和污垢;刚买的食物、书报等东西,也有可能把外界的脏物带进包里。时间一久,包包就成为了可怕的藏污纳垢之王,急需清理。
解决方法:每月清洁常用的包。如果是昂贵的真皮包,千万不能胡乱清洁,因为一般的有机溶剂可能会破坏它的光泽和柔软度,最好用专门的皮革清洁剂。至于包包的内部布面,可以把里料整个翻折出来,用旧牙刷等小刷子把里料的表面和边缝都刷干净,再用棉布蘸取清洁剂擦拭一遍,随后阴干即可。
如果是环保的棉布包,就可以把包包的内侧翻到外面,然后直接扔到洗衣机里洗,或者用洗衣粉和肥皂刷洗也可以。可以用“包中包”来帮助包包清洁,比如化妆品、数码产品、书籍等各自归入一个小包,这样不仅方便寻找和取用,还能让包包干净整齐,再也不要把所有东西都乱扔进包了。
精彩阅读:最坑人的8种“健康食品” 让你女人越吃越年轻的食物
编辑推荐:补脑必吃的十种健康食物
手机可以说是和我们最亲密的数码产品了,不管是坐车、上班、吃饭、逛街,我们总是把手机拿在手里不放,因此,手机上的细菌数量非常惊人,虽然看不见也摸不着,但你一定不能“无视”它,因为它实在离我们太近了。
解决方法:每周清水擦拭。关于手机的清洁,最推荐的还是纸巾、棉布或眼镜布蘸少量水擦拭。最多用不超过75%的酒精擦,而手机屏幕绝对不可以用酒精。另外,绝对不要把手机带上床,不仅会对大脑产生辐射,更会把细菌传上床。而如果你的他上床前摸过手机,一定要请他洗过手才能碰你。另外,一定要用手机袋。
我们的手每天都在超级频繁地触摸键盘和鼠标,上面的细菌种类繁多、数量庞大,如果没有及时清理,手再到处乱摸的话,会导致消化道疾病、皮肤病以及眼病等。曾有一项调查发现,办公室电脑键盘里的垃圾正以平均每月2克的速度增加。
解决方法:隔天清理。先把键盘整个倒过来拍打摇晃一下,倒出里面的“陈年存货”,灰尘、食物碎屑、头发、皮屑等都是键盘里的“常客”,你也可以拿电吹风对着键盘的缝隙吹一通,加强清洁。然后用棉布蘸上酒精或清水擦拭键盘和鼠标,再把表面残余的水渍擦干。另外,如果洗完澡后还使用了键盘、鼠标之类的用品,那么在睡觉前一定要洗手。
现在很多女性都有去瑜伽馆运动的好习惯,瑜伽运动有很多需要用身体紧贴垫子的体式,甚至还有头脸部直接碰触垫子的体式,但公共场合总是很难保证卫生,千人踩过万人踏过的瑜伽垫更是各种细菌云集的地方。
解决方法:自带铺巾最干净。自带瑜伽垫的话太大太重了,不太方便,而且瑜伽垫本身也不容易清洁,所以还是建议大家自带一条瑜伽铺巾,铺巾的正面是平整的布面,而背面则是防滑的塑胶颗粒,铺在瑜伽馆的垫子上,既能保证如自家般干净,又能防滑,也不会太重,回家后直接清洗就可以了。
精彩阅读:最坑人的8种“健康食品” 让你女人越吃越年轻的食物